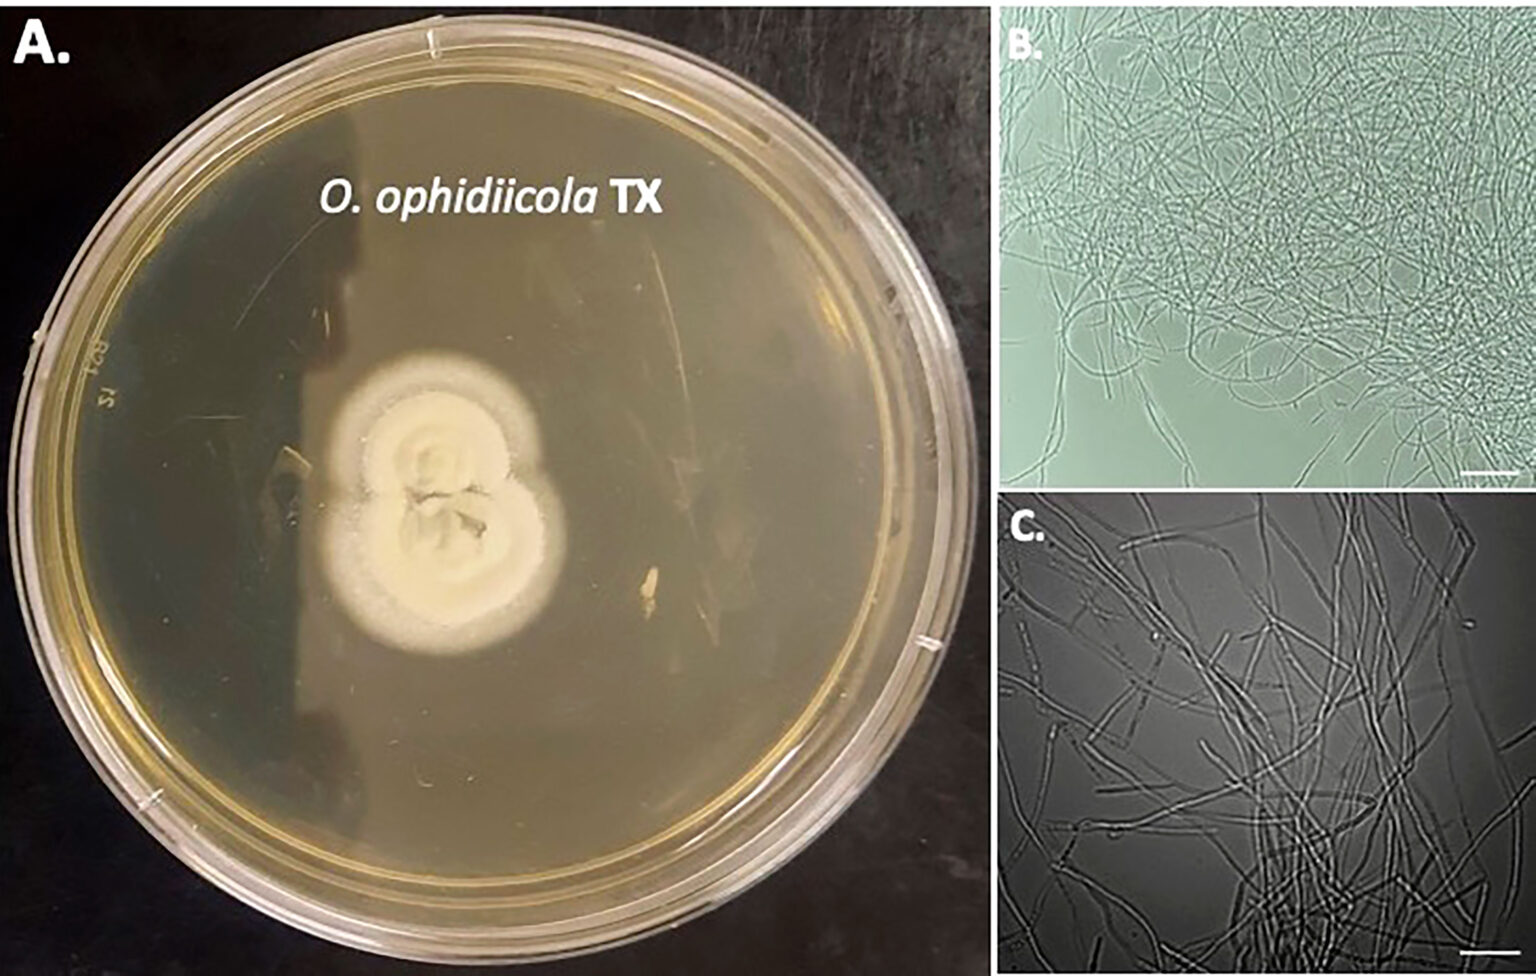
snake-shedding-growth-fungal disease-biologists-biological defense

تصور کنید اگر مجبور بودید هر چند ماه یک بار لایهای کامل از پوست خود را رها کنید، چه احساسی داشتید؟ این واقعیت شگفتانگیز و منحصربهفرد اما بخشی جدانشدنی از زندگی مارهاست. پوستاندازی، فرایندی است که به مارها امکان رشد، دفاع در برابر بیماریها و احیای سلولهای پوست را میدهد. در این مقاله، از عمق علمی این پدیده پرده برمیداریم و اهمیت آن را برای زندگی مارها بررسی میکنیم.
پوست مار: ساختاری هوشمندانه برای بقا
پوست مارها از دو لایه اصلی به نامهای اپیدرم و درم تشکیل شده است. اپیدرم همان لایه خارجی و سخت پوست است که از کراتین ساخته شده و فلسهای مار را شکل میدهد. اما این لایه سخت و غیرقابل انبساط است، به این معنی که با رشد مار، نیاز به جایگزینی دارد. همین نقطه است که پوستاندازی به میان میآید.
«مارها برخلاف انسانها، پوستهای کامل و ساختاریافته از خود جدا میکنند؛ فرایندی که نه تنها برای رشد، بلکه برای دفاع در برابر عوامل بیماریزا حیاتی است.»
– جیسون دالاس، پژوهشگر تعاملات زیستی خزندگان
لایه درم که در زیر اپیدرم قرار دارد، حاوی رنگدانهها و طرحهایی است که زیبایی و ویژگیهای استتاری مار را به او هدیه میدهد. این دو لایه در هماهنگی کامل عملکرد پوست مار را مدیریت میکنند.
چرا مارها پوستاندازی میکنند؟
پوستاندازی برای مارها یک واکنش طبیعی به محدودیتهای بیولوژیکی بدن آنهاست. لایه بیرونی پوست مار به دلیل عدم انعطافپذیری باید بهطور مرتب جایگزین شود تا بدن در حال رشد بتواند به ابعاد بزرگتر برسد. این فرایند در دوران جوانی، بهویژه وقتی مارها با سرعت بیشتری رشد میکنند، بسیار مکرر رخ میدهد.
به گفته دانیل کین، کارشناس ارشد خزندگان: «اولین پوستاندازی مار تنها چند روز پس از تولد رخ میدهد و با افزایش سن، تعداد این فرایند کاهش مییابد، اما متوقف نمیشود.»
مراحل پوستاندازی؛ از آغاز تا پایان
پوستاندازی در مارها از تولید لایهای جدید از کراتین آغاز میشود. مایعی مخصوص بین پوست جدید و قدیمی ترشح میشود تا به جداسازی آن کمک کند. سپس مار با مالیدن سر خود به یک سطح زبر، شکافی کوچک ایجاد میکند و با انقباض عضلات بدن، بهتدریج از پوست کهنه خارج میشود. این فرایند میتواند از چند ساعت تا چند روز به طول بیانجامد.
جالب اینجاست که پوست تازه در ابتدا نرم و کشسان است و حتی طول بدن مار را بلندتر نشان میدهد. پس از مدتی، این لایه خشک و مقاوم میشود و به محافظ قدرتمند مار تبدیل میشود.
پوستاندازی؛ بیش از یک فرایند رشد
جدا از مسئله رشد، پوستاندازی نقش دیگری در دفاع بیولوژیکی مار ایفا میکند. این فرایند به مارها اجازه میدهد تا انگلها، باکتریها و قارچهای مضر را از سطح بدن خود بزدایند. یکی از چالشهای زیستی مارها، بیماری قارچی است که میتواند به پوست، چشم و حتی سیستم عصبی آنها آسیب برساند.
«پوستاندازی به مارها کمک میکند تا خود را از شر عوامل بیماریزا رها کرده و سلامت بدن را بازیابی کنند.»
– دونالد واکر، استاد زیستشناسی
بااینوجود، هر فرایند پوستاندازی هزینههای زیستی خود را دارد. کاهش قدرت دید و انرژی مصرفشده در این دوران میتواند مار را در معرض خطر شکارچیان قرار دهد. به همین دلیل، بسیاری از گونهها این فرایند را در شرایطی امن و دور از تهدید انجام میدهند.
اطلاعات حاصل از پوستهای رهاشده
پوستهای رهاشده مارها اطلاعات ارزشمندی برای محققان و زیستشناسان فراهم میکنند. الگوهای باقیمانده روی پوست میتواند به شناسایی گونهها، بررسی جمعیت و حتی تحلیل سلامت مارها کمک کند. این امر به محافظت از گونههای در خطر و توسعه استراتژیهای پایدار محیطزیستی نیز یاری میرساند.
مارها و مقایسه با دیگر خزندگان
هرچند بسیاری از خزندگان نیز فرآیند پوستاندازی دارند، مارها در میان آنها به دلیل ایجاد پوستهای کامل و یکپارچه منحصربهفرد هستند. برخی مارمولکها مانند اعضای سردهی ابرونیا پوستهای ساختاریافته مشابهی رها میکنند؛ اما بیشتر خزندگان، پوست را در تکههای کوچک جدا میکنند.
افکار پایانی
پوستاندازی پدیدهای بیمانند است که به مارها توان بقای بیشتری در طبیعت میبخشد. این فرایند با تمامی چالشها و فوایدش، نهتنها به رشد و سلامت مارها کمک میکند، بلکه اطلاعات ارزشمندی را برای جامعه علمی فراهم آورده است. زندگی این خزندگان پیچیدگیهای شگفتآوری دارد که ما را به درک عمیقتر از جهان طبیعی دعوت میکند.
نظر شما در مورد این فرایند شگفتانگیز چیست؟ آیا تا به حال از پوستاندازی حیوانات در زندگی یا تحقیقهای خود الهام گرفتهاید؟ نظرات خود را با ما به اشتراک بگذارید و در این بحث جذاب شرکت کنید!

دیدگاه ها